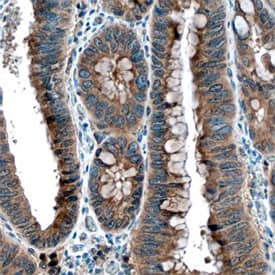
TACE/ADAM17 antibody in Human Colon by Immunohistochemistry (IHC-P).

Human TACE/ADAM17 Antibody
R&D Systems, part of Bio-Techne | Catalog # AF9301


Key Product Details
Species Reactivity
Validated:
Cited:
Applications
Validated:
Cited:
Label
Antibody Source
Product Specifications
Immunogen
Arg215-Asn671
Accession # P78536
Specificity
Clonality
Host
Isotype
Scientific Data Images for Human TACE/ADAM17 Antibody
Detection of Human TACE/ADAM17 by Western Blot.
Western blot shows lysates of human heart tissue. PVDF membrane was probed with 1 µg/mL of Goat Anti-Human TACE/ADAM17 Antigen Affinity-purified Polyclonal Antibody (Catalog # AF9301) followed by HRP-conjugated Anti-Goat IgG Secondary Antibody (Catalog # HAF019). A specific band was detected for TACE/ADAM17 at approximately 100 kDa (as indicated). This experiment was conducted under reducing conditions and using Immunoblot Buffer Group 1.TACE/ADAM17 in Human Colon.
TACE/ADAM17 was detected in immersion fixed paraffin-embedded sections of human colon using Goat Anti-Human TACE/ADAM17 Antigen Affinity-purified Polyclonal Antibody (Catalog # AF9301) at 3 µg/mL overnight at 4 °C. Before incubation with the primary antibody, tissue was subjected to heat-induced epitope retrieval using Antigen Retrieval Reagent-Basic (Catalog # CTS013). Tissue was stained using the Anti-Goat HRP-DAB Cell & Tissue Staining Kit (brown; Catalog # CTS008) and counterstained with hematoxylin (blue). Specific staining was localized to epithelial cells. View our protocol for Chromogenic IHC Staining of Paraffin-embedded Tissue Sections.Applications for Human TACE/ADAM17 Antibody
Immunohistochemistry
Sample: Immersion fixed paraffin-embedded sections of human colon
Western Blot
Sample: Human heart tissue
Reviewed Applications
Read 1 review rated 5 using AF9301 in the following applications:
Formulation, Preparation, and Storage
Purification
Reconstitution
Formulation
Shipping
Stability & Storage
- 12 months from date of receipt, -20 to -70 °C as supplied.
- 1 month, 2 to 8 °C under sterile conditions after reconstitution.
- 6 months, -20 to -70 °C under sterile conditions after reconstitution.
Background: TACE/ADAM17
TACE is a member of the ADAM family that contains A Disintegrin And Metalloprotease-like domain. Like other membrane-anchored ADAMs, TACE consists of a pro domain with a cysteine switch and furin cleavage sequence, a catalytic domain with the zinc-binding site and Met-turn expected for reprolysins, a disintegrin-like domain, a cysteine-rich domain, an EGF-like domain, a transmembrane domain, and the cytoplasmic domain. In addition to its ability to release the 17 kDa extracellular form of tumor necrosis factor-alpha (TNF-alpha) from the 26 kDa membrane-anchored TNF-alpha, TACE also plays an essential role in shedding ectodomains from a variety of proteins such as L-Selectin, Transforming Growth Factor-alpha, Amyloid Protein Precursor, and Notch-1 receptor. TACE mRNA is present in virtually every tissue and TACE protein resides both on the cell surface and in the cell.
References
- Black, R.A. and J.D. Becherer (1998) in Tumor Necrosis Factor alpha-Converting Enzyme. Barrett, A.J. et al. (eds): Handbook of Proteolytic Enzymes, San Diego: Academic Press, p. 1315.
- Primakoff, P. and D.G. Myles (2000) Trends in Genetics 16:83.
Long Name
Alternate Names
Gene Symbol
UniProt
Additional TACE/ADAM17 Products
Product Documents for Human TACE/ADAM17 Antibody
Product Specific Notices for Human TACE/ADAM17 Antibody
For research use only